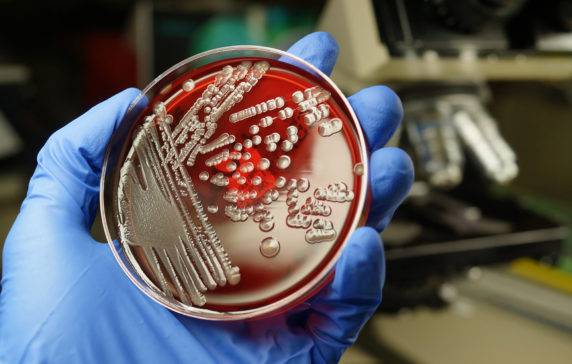

The 2023 Tech Trends Roundtable
Article Metadata
Jan 9, 2023
Powerful AI-driven discovery, research and insight tools
Personal AI-powered insights on any web page
Instant insights, in the moment
Unique insight and data, plus the creativity of generative AI
Data and insight on 10M+ companies
Data and insight on 1,500+ markets
Like a team of researchers working 24/7 — just for you
National science-backed data science on private companies
Concise, precise visual research that drives decisions
Double-verified, continually refreshed
Market intelligence accessible to AI and agents in real time
Insights that live where you works
Append or add CB Insights data right into Salesforce
Rare data, real edge, right now
Make your AI smarter with our data and tools